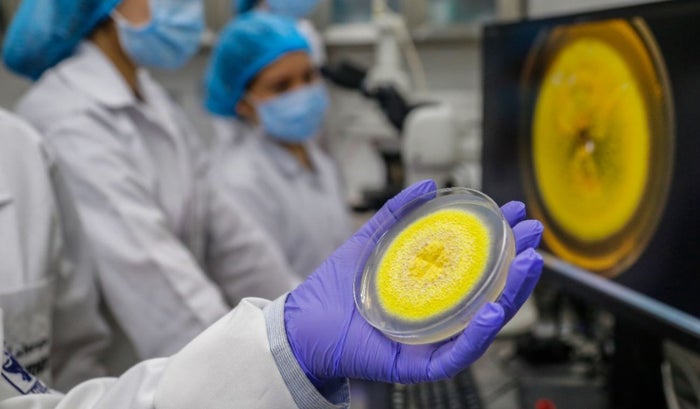

Un grupo investigativo de la Universidad de Santander (Udes) y la Universidad Eafit descubrieron un nuevo hongo capaz de absorber el cadmio, un metal pesado que causa graves problemas de salud como el cáncer en humanos.
El hallazgo se dio en zona rural del municipio San Vicente de Chucurí en Santander, y fue nombrado ‘Talaromyces santanderensis’ tras ser encontrado en un cultivo de cacao en una finca productora.
En el proceso los investigadores se sorprendieron al ver que el microorganismo podía crecer en altas concentraciones de cadmio, mientras que las demás especies morían.
Sobre este tema la doctora Beatriz Helena Guerra Sierra, investigadora y profesora de la Udes, aseguró que el hongo puede sobrevivir en entornos altamente contaminados por cadmio, muy por encima de los valores registrados en terrenos afectados donde se cultivan hortalizas y cereales, incluyendo cacao, arroz, tomate y lechuga.
Lea También: Reforma rural y agraria avanza a tercer debate en el Congreso
“Nos dimos cuenta que se trataba de una especie nueva para la ciencia. Representa una esperanza para seguir trabajando y hallar los genes que tiene el hongo para acumular y vivir en estos suelos tan contaminados”, expresó la líder de la investigación.
Hasta ahora solo han clasificado cinco hongos de esta especie en Colombia y este es el primero que se identificó como acumulador de cadmio. El microorganismo se encarga de atrapar el cadmio para evitar que pase a la planta, como una esponja y absorbe el elemento contaminante.
“Aclarando que el cadmio no solo se encuentra en los cultivos de cacao, también en el arroz, en cualquier otro cultivo de hortalizas. Lo que pasa es que hay muy pocos estudios destinados a revisar el papel que cumplen estos hongos en los suelos”, añadió Guerra Sierra.
Con el descubrimiento se espera contar con nuevas herramientas para plantear futuras estrategias y descontaminar los suelos agrícolas del país. Ya que este tipo de hongos impactan negativamente la comercialización de cacao, pues las exportaciones no se pueden realizar si se evidencia contaminación con metales pesados.
Tras la publicación del descubrimiento científicos de otras partes del mundo, como investigadores franceses, se sintieron atraídos por el particular color amarillo limón de este hongo, por lo que los estudios del nuevo microorganismo no tendrán límite. “Esta especie acumula cadmio, pero también puede producir otras sustancias que pueden servir para otras funciones. Incluso se podrían estudiar propiedades antibióticas o antiparasitarias”.